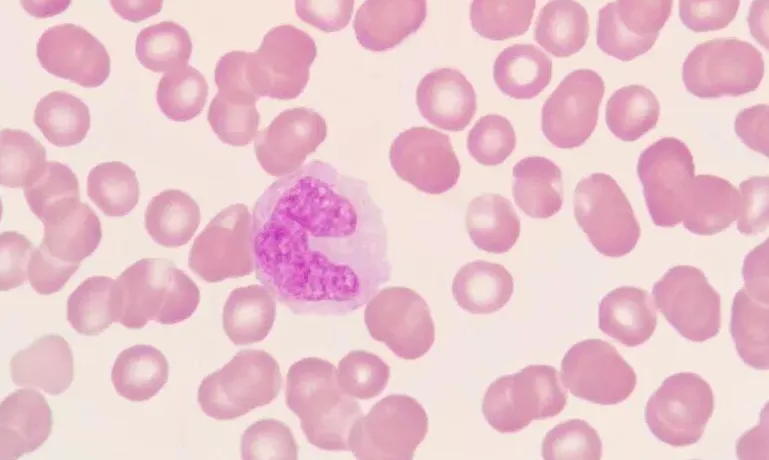

盯住这个指标!一旦它持续上涨,就说明病情可能在往白血病方向进展了

我是血液科杨淑莲医生,专攻血液病中医调理40余年,能在茫茫人海相遇是难得的缘分,如果你正被血液病困扰,或许我能帮上你,让你在治疗路上少走弯路。
很多人查血常规,只盯着白细胞、血小板、血红蛋白这三项,觉得只要这三项没大问题就可以安心,确实也没问题。但是,血常规里还有一个指标也很关键,这个指标就是——单核细胞。
单核细胞,盯紧了!
单核细胞是白细胞家族里的一个重要成员,大概占白细胞总数的3%~8%。它充当身体里的”清道夫”和”通讯兵” —— 负责吞噬细菌病毒碎片、传递免疫信息、协助其他免疫细胞“干活”。
如果,单核细胞数值在短期内持续升高,一升就是好几个月,这事儿就不对劲了。
单核细胞持续上涨是一种“危险信号”,这说明病情可能在往白血病方向进展了。
怎么理解?
你可以把身体想象成一个“防御系统”,白细胞是“主力军”,负责对抗细菌、病毒这些“敌人”。而单核细胞,就是白细胞里的“特种部队”,正常情况下,它的数量很少,帮身体清理垃圾、对抗少量“敌人”。
可一旦单核细胞开始疯狂增多,持续上涨,就说明情况不对了,它不再是正常的“防御兵”,而是被“坏细胞”同化,变成了白血病的“先头部队”。简单说,单核细胞持续上涨,就是身体在给你发“警报”:再不管,病情就要奔白血病方向去了!
单核细胞持续升高,还可能意味着:– 慢性感染(比如:结核)– 自身免疫性疾病(比如:红斑狼疮)– 血液系统疾病(比如:骨髓增生异常综合征(mds)、慢性髓单核细胞白血病)
研究表明:– 如果单核细胞绝对值持续超过1×10⁹/L,且超过3个月以上,需要警惕慢性髓单核细胞白血病(CMML)的可能。– 老年人群中,单核细胞持续升高者,3年内发生血液系统恶性肿瘤的风险增加5倍。– 在急性单核细胞白血病(M5型)中,单核细胞占比可以达到80%以上。
白血病不是突然就得的,大多都有一个“预警期”,而单核细胞就是这个预警期里最明显的“信号兵”。
很多病友去查了血常规,看到白细胞稍微高点,觉得没多大点事儿。但是,太多病友可能也没有在意的是:单核细胞的绝对值和比例也正在悄悄往上爬。
忽略了这个不起眼的指标,结果等到真正确诊的时候,已错过最佳干预时机。
病例分享
59岁的程女士,确诊mds,去年开始反复低烧、浑身乏力,还总觉得喉咙不舒服,去医院复查了血常规,对比后才发现单核细胞从之前的5%涨到了15%,当地医生告诉她,这是明显的进展信号,再不控制住,很快就会转成急性白血病。后来通过病友找到我,开始通过中医扶正清毒、养髓通络的方法对症调理,重点在于抑制单核细胞上涨,同时护住骨髓、稳住体质。经疗程调理数月后,她的单核细胞指标成功降到了8%,低烧、乏力等不适症状也好转了。再继续坚持巩固调理了半年,指标一直稳定在正常范围,整体病情也没往坏的方向发展。
提醒
单核细胞偶尔涨一点,可能是感冒、炎症引起的,不用恐慌。但如果连续2~3次复查,单核细胞都在持续上涨,一次比一次高,没有下降的趋势,哪怕每次只涨1~2%都不能掉以轻心,这不是小事,一定要立刻找专业血液科医生制定调理方案。

中医调理思路
从中医角度来说,单核细胞持续上涨,本质就是体内“毒热内蕴、痰瘀互结”,骨髓造血功能紊乱,导致“坏细胞”疯狂增殖。中医调理的核心,就是健脾补肾、填精养髓,先帮患者把骨髓这个“造血工厂”修复好,同时温和清毒、化瘀通络,把患者体内的“坏细胞”抑制住,让单核细胞慢慢降下来、稳住。
我是中医血液病专家杨淑莲医生 从事血液病诊疗与研究工作40余年,临床经验丰富,40多年我只做一件事:用专业的中医知识,帮助血液病患者恢复正常生活。其独创的“临证五法”诊疗体系,运用“温、清、消、补、和”,可针对不同病证,辨证论治,中医临床屡获良效。能在茫茫人海相遇是难得的缘分,如果你正被血液病困扰,或许我能帮上你,让你在治疗路上少走弯路。

杨淑莲,国家级名老中医,享受国务院特殊津贴专家,河北省首届名中医,主任中医师,二级教授,北京电视台《养生堂》特邀血液病专家,十二五国家临床重点专科(血液学科)带头人,42年临床诊疗经验。
擅长:免疫性血小板减少症(ITP)、原发性血小板增多症、真性红细胞增多症、再生障碍性贫血(再障)、急性髓系白血病、急性淋巴细胞白血病、慢性粒细胞白血病、骨髓增生异常综合征(MDS)、原发性骨髓纤维化、多发性骨髓瘤、恶性淋巴瘤及各类贫血。

扫上方二维码 添加好友 留言问题
不想错过精彩内容,点击关注杨淑莲医生的公众号
星标🌟“杨淑莲血液说”🌟及时接收杨医生的最新动态!
来源:“杨淑莲血液说”公众号。
声明:本文仅用于学习交流,版权归作者所有。部分图片源于网络,侵删!
欢迎转载,转载请注明出处“杨淑莲血液说”

喜欢,就点个“在看”
 点击「阅读原文」血液问题免费指导!
点击「阅读原文」血液问题免费指导!  夜雨聆风
夜雨聆风





